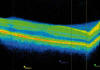

SEMINARIO DE CASOS CLÍNICOS
Síndrome AZOOR. Hallazgos con tomografía de coherencia óptica
Ancochea Díaz G1, Rodríguez Hernández CF
Servicio de Oftalmología. Hospital «Infanta
Cristina». Parla. Madrid.
1
Licenciado en Medicina.
RESUMEN
Introducción: El síndrome AZOOR (acute zonal occult outer retinopathy), de etiología desconocida, se caracteriza por una disfunción aguda de las capas externas de la retina que origina escotomas con preferencia central o aumento de mancha ciega, acompañados de fotopsias.
Caso clínico: Presentamos el caso de una mujer de 41 años que acude a Urgencias por aparición de escotoma y fotopsias en OI. En la exploración se objetivó disminución de la agudeza visual y un leve defecto pupilar aferente relativo en ese ojo, así como un escotoma centrocecal en la campimetría. Tras descartar patología neurooftalmológica, se realizó tomografía de coherencia óptica (OCT) hallándose interesantes cambios a nivel de las capas externas de la retina en la zona correspondiente al escotoma.
Palabras clave: Retinopatía aguda zonal oculta externa, AZOOR, tomografía de coherencia óptica.
INTRODUCCIÓN
El síndrome AZOOR (acute zonal occult outer retinopathy), descrita por Gass en 1993 (1), es una entidad de etiología desconocida que se caracteriza por una disfunción aguda, habitualmente unilateral (no siendo raro afectación secuencial de 2.º ojo), de las capas externas de la retina en una o más zonas retinianas. Tiene notables coincidencias con otros cuadros como el síndrome de múltiples manchas blancas evanescentes, el síndrome de agrandamiento idiopático de la mancha ciega, la neuroretinopatía macular aguda, la coroiditis multifocal y el síndrome de presunta histoplasmosis ocular. Afecta predominantemente a mujeres jóvenes y clínicamente se caracteriza por la aparición de escotomas con preferencia central o pericecal acompañados de fotopsias. Los cambios iniciales en el fondo de ojo son mínimos o inexistentes y el electrorretinograma (ERG) está alterado (2).
CASO CLÍNICO
Mujer de 41 años que acude a Urgencias por escotoma y fotopsias en el área del escotoma en OI de pocos días de evolución, sin dolor ni otra sintomatología acompañante. El único antecedente de interés es un episodio de inflamación orbitaria idiopática izquierda 11 años antes.
En la exploración la agudeza visual sin corrección era de 1 en ojo derecho y 0,3 en OI que mejoraba a 0,7 con -0.25 -1.75 a 180°. Presentaba un defecto pupilar aferente relativo. Biomicroscópicamente el polo anterior era normal. En el fondo de ojo no se encontraron anomalías. Se realizó tomografía de coherencia óptica (OCT) de capa de fibras nerviosas sin encontrarse alteraciones. En una campimetría 24-2 SITA fast se apreciaba un escotoma centrocecal más profundo en zona pericecal en OI (fig. 1).

Fig. 1: Primer CV donde se observa escotoma centrocecal.
Con sospecha de neuritis retrobulbar atípica se cursó interconsulta a neurología y se realizaron estudios analíticos, incluyendo serología luética, anticuerpos antinucleares, anticitoplasma de neutrófilos, enzima conversora de angiotensina y Mantoux, que fueron negativos.
Se solicitó resonancia magnética de órbitas y cerebral con contraste, hallándose lesiones puntiformes inespecíficas en sustancia blanca de los lóbulos frontales, pero que no eran sugestivas de desmielinización.
Fig. 2: OCT en momento del debut OD (sano).
Los potenciales evocados visuales fueron simétricos y sin alteraciones en amplitudes ni latencias. Se realizó OCT de mácula encontrándose un aumento de señal a nivel de la capa plexiforme externa, así como atenuación de la capa de los fotorreceptores a nivel de fóvea, que en la zona nasal llegaba a desaparecer (fig. 3). En la evolución se observó además adelgazamiento de la capa plexiforme externa, más llamativa allí donde el escotoma era más profundo (fig. 4). Se completó el estudio con una angiofluoresceingrafía (AFG), en la que únicamente se apreciaba leve hiperfluorescencia peripapilar por efecto ventana y tinción en fases tardías en OI (fig. 5).

Fig. 3: OCT en el momento del debut OI: Se objetiva aumento de señal en
plexiforme externa y atenuación-desaparición de fotorreceptores más llamativa
cuanto más nasal.

Fig. 4: OCT OI a los 3 meses del debut: Se puede ver mayor adelgazamiento en las
capas externas nasales que en la figura 3.

Fig. 5: AFG: Se observa hiperfluorescencia peripapilar por efecto ventana en
fases precoces y tinción en las tardías.
En base a estos hallazgos diagnosticamos a la paciente de síndrome AZOOR tipo aumento idiopático de la mancha ciega. A los 3 meses la agudeza visual alcanzaba la unidad en OI y el escotoma había disminuido de tamaño, si bien prácticamente no existió mejoría en aquellos puntos que habían mostrado una sensibilidad de 0 y persistieron las fotopsias (fig. 6).

Fig. 6: CV a los 3 meses del debut. El escotoma se ha reducido.
DISCUSIÓN
El síndrome AZOOR es un trastorno raro de predominio en mujeres jóvenes y etiopatogenia desconocida que relaciona distintos cuadros que comparten la afectación aguda de un área o múltiples de la retina con disfunción de fotorreceptores y capas externas, con un posible, hipotético y controvertido mecanismo etiopatogénico común.
El fondo de ojo es normal o presenta áreas con mínimas alteraciones pigmentarias a nivel del epitelio pigmentario de la retina (EPR) y estrechamiento vascular retiniano más evidentes en la evolución. No existen síntomas inflamatorios en el segmento anterior, siendo nula o escasa la celularidad vitrea. La falta de hallazgos funduscópicos y la posibilidad de presentar defecto pupilar, hace que estos cuadros puedan ser confundidos con otros procesos y sean etiquetados frecuentemente de neuritis retrobulbar atípica.
La AFG es normal, o presenta un efecto ventana en el área de atrofia del epitelio pigmentario en fases evolucionadas. El electrorretinograma (ERG) presenta alteraciones con afectación de la onda a y b, mostrando una afectación del complejo fotorreceptor-epitelio pigmentario, que se correlaciona con el campo visual, afectándose más la respuesta de conos (3).
En la OCT se ha encontrado una buena correlación entre alteraciones estructurales y los escotomas. La alteración típica descrita es una atenuación o desaparición de la banda hiperreflectante correspondiente a la unión entre segmento interno y externo de fotorreceptores, si bien también ha sido descrita una afectación de la capa plexiforme externa, al igual que en nuestro caso (4). Los tomógrafos de coherencia óptica de última generación han mostrado una buena sensibilidad a la hora de detectar estas alteraciones, superior a los modelos previos (5).
Ningún tratamiento ha demostrado efectividad en estos pacientes, si bien se ha probado con corticoides, antivíricos, inmunosupresores y antifúngicos (6). En la evolución, las alteraciones campimétricas suelen permanecer estables o presentar una discreta reducción de los escotomas. Pocas veces progresan y rara vez se produce normalización del CV en casos con afectación funcional discreta. En la serie de Gass et al está descrito un 31% de recurrencias (7).
CONCLUSIÓN
Se ha considerado a la ERG como una prueba fundamental en el diagnóstico de este cuadro y su diferenciación de patología retrobulbar del nervio óptico (2), pero no está disponible en la mayoría de los centros.
La OCT nos permite localizar el daño estructural en los segmentos externos retinianos presente en estos pacientes. En cuadros con alta sospecha clínica, puede ser la clave diagnóstica de este trastorno ante la falta de disponibilidad de la ERG.
BIBLIOGRAFÍA
-
Gass JD (1993). Acute zonal occult outer retinopathy. Donders Lecture. The Netherlands Ophthalmological Society, Maastricht, 19 June 1992. J Clin Neuroophthalmol 13: 79-97.
-
Jacobson SG, Morales DS, Sun XK, Feuer WJ, Cideciyan AV, Gass JD, et al. Pattern of retinal dysfunction in acute zonal occult outer retinopathy. Ophthalmology 1995; 102: 1187-1198.
-
Francis PJ, Marinescu A, Fitzke FW, Bird AC, Holder GE. Acute zonal occult outer retinopathy: towards a set of diagnostic criteria. Br J Ophthalmol 2005; 89: 70-73.
-
Li D, Kishi S. Loss of photoreceptor outer segment in acute zonal occult outer retinopathy. Arch Ophthalmol. 2007; 125(9): 1194-2000.
-
Takai Y, Ishiko S, Kagokawa H, Fukui K, Takahashi A, Yoshida A. Morphological study of acute zonal occult outer retinopathy (AZOOR) by multiplanar optical coherence tomography. Acta Ophthalmol. 2009; 87: 408-18.
-
Carrasco L, Ramos M, Galisteo R, Pisa D, Fresno M, Gonzalez ME. Isolation of Candida famata from a patient with acute zonal occult outer retinopathy. J Clin Microbiol 2005; 43: 635-640.
-
Gass JD, Agarwal A, Scott IU. Acute zonal occult outer retinopathy: a long-term follow-up study. Am J Ophthalmol. 2002; 134(3): 329-39.